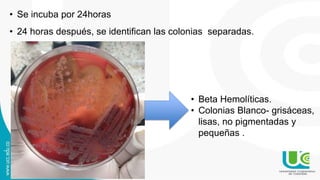
• Se incuba por 24horas
• 24 horas después, se identifican las colonias separadas.
• Beta Hemolíticas.
• Colonias Blanco- grisáceas,
lisas, no pigmentadas y
pequeñas .
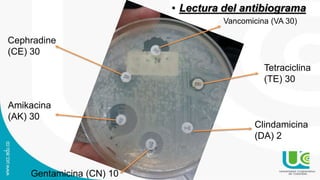
• Lectura del antibiograma
Vancomicina (VA 30)
Tetraciclina
(TE) 30
Clindamicina
(DA) 2
Cephradine
(CE) 30
Amikacina
(AK) 30
Gentamicina (CN) 10

Un canino de raza Bulldog de 9 meses fue llevado a un centro clínico veterinario por zonas alopécicas con abscesos. Se tomó una muestra de uno de los abscesos y se identificó Staphylococcus intermedium, una bacteria habitual de la piel canina que puede causar infecciones cuando las defensas del huésped están disminuidas. El antibiograma mostró resistencia a varios antibióticos comunes.